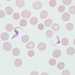
Trypanosomiasis, African
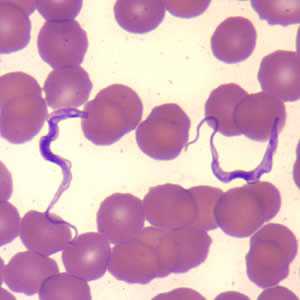
Trypanosomiasis, African
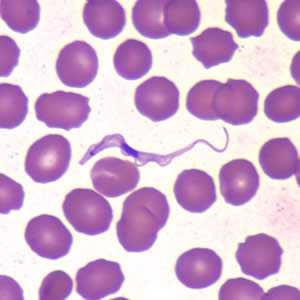
Trypanosomiasis, African

Trypanosomiasis, African
[Trypanosoma brucei gambiense] [Trypanosoma brucei rhodesiense]
Causal Agents
Protozoan hemoflagellates belonging to the complex Trypanosoma brucei. Two subspecies that are morphologically indistinguishable cause distinct disease patterns in humans: T. b. gambiense causes West African sleeping sickness and T. b. rhodesiense causes East African sleeping sickness. (A third member of the complex, T. b. brucei, under normal conditions does not infect humans.
Life Cycle

During a blood meal on the mammalian host, an infected tsetse fly (genus Glossina) injects metacyclic trypomastigotes into skin tissue. The parasites enter the lymphatic system and pass into the bloodstream  . Inside the host, they transform into bloodstream trypomastigotes
. Inside the host, they transform into bloodstream trypomastigotes  , are carried to other sites throughout the body, reach other body fluids (e.g., lymph, spinal fluid), and continue the replication by binary fission
, are carried to other sites throughout the body, reach other body fluids (e.g., lymph, spinal fluid), and continue the replication by binary fission  . The entire life cycle of African trypanosomes is represented by extracellular stages. The tsetse fly becomes infected with bloodstream trypomastigotes when taking a blood meal on an infected mammalian host
. The entire life cycle of African trypanosomes is represented by extracellular stages. The tsetse fly becomes infected with bloodstream trypomastigotes when taking a blood meal on an infected mammalian host  ,
,  ). In the fly’s midgut, the parasites transform into procyclic trypomastigotes, multiply by binary fission
). In the fly’s midgut, the parasites transform into procyclic trypomastigotes, multiply by binary fission  , leave the midgut, and transform into epimastigotes
, leave the midgut, and transform into epimastigotes  . The epimastigotes reach the fly’s salivary glands and continue multiplication by binary fission
. The epimastigotes reach the fly’s salivary glands and continue multiplication by binary fission  . The cycle in the fly takes approximately 3 weeks. Humans are the main reservoir for Trypanosoma brucei gambiense, but this species can also be found in animals. Wild game animals are the main reservoir of T. b. rhodesiense.
. The cycle in the fly takes approximately 3 weeks. Humans are the main reservoir for Trypanosoma brucei gambiense, but this species can also be found in animals. Wild game animals are the main reservoir of T. b. rhodesiense.
Geographic Distribution
T. b. gambiense is found in foci in large areas of West and Central Africa. The distribution of T. b. rhodesiense is much more limited, with the species found in East and Southeast Africa.
Clinical Presentation
Infection occurs in 3 stages. A trypanosomal chancre can develop on the site of inoculation. This is followed by a hemolymphatic stage with symptoms that include fever, lymphadenopathy, and pruritus. In the meningoencephalitic stage, invasion of the central nervous system can cause headaches, somnolence, abnormal behavior, and lead to loss of consciousness and coma. The course of infection is much more acute with T. b. rhodesiense than T. b. gambiens.
Trypansoma brucei ssp. in thick blood smear stained with Giemsa.
The two Trypanosoma brucei subspecies that cause African trypanosomiasis, T. b. gambiense and T. b. rhodesiense, are indistinguishable morphologically. A typical trypomastigote has a small kinetoplast located at the posterior end, a centrally located nucleus, an undulating membrane, and a flagellum running along the undulating membrane, leaving the body at the anterior end. Trypomastigotes are the only stage found in patients. Trypanosomes range in length from 14 to 33 &m.

Figure A: Trypansoma brucei ssp. in a thick blood smear stained with Giemsa.

Figure B: Trypansoma brucei ssp. in a thick blood smear stained with Giemsa.

Figure C: Trypansoma brucei ssp. in a thick blood smear stained with Giemsa.
Trypansoma brucei ssp. in thin blood smears stained with Giemsa.

Figure A: Trypanosoma brucei ssp. in a thin blood smear stained with Giemsa.

Figure B: Trypanosoma brucei ssp. in a thin blood smear stained with Giemsa.
Figure C: Trypomastigotes of T. brucei ssp. in a blood smear stained with Giemsa.

Figure D: Trypomastigotes of T. brucei ssp. in a blood smear stained with Giemsa.
Trypansoma brucei ssp. in thin blood smears stained with Wright-Giemsa.

Figure A: Trypanosoma brucei ssp. in a thin blood smear stained with Wright-Giemsa.

Figure B: Trypanosoma brucei ssp. in a thin blood smear stained with Wright-Giemsa.
Figure C: Trypanosoma brucei ssp. in a thin blood smear stained with Wright-Giemsa.

Figure D: Trypanosoma brucei ssp. in a thin blood smear stained with Wright-Giemsa.
Figure E: Trypanosoma brucei in a thin blood smear stained with Wright-Giemsa.

Figure F: Trypanosoma brucei ssp. in a thin blood smear stained with Wright-Giemsa.
Trypanosoma brucei ssp. in thin blood smear, beginning to divide.

Figure A: Trypanosoma brucei ssp. in a thin blood smear stained with Giemsa. The trypomastigote is beginning to divide; dividing forms are seen in African trypanosomes, but not in American trypanosomes.
Laboratory Diagnosis
The diagnosis rests upon demonstrating trypanosomes by microscopic examination of chancre fluid, lymph node aspirates, blood, bone marrow, or, in the late stages of infection, cerebrospinal fluid. A wet preparation should be examined for the motile trypanosomes, and in addition a smear should be fixed, stained with Giemsa (or Field), and examined. Concentration techniques can be used prior to microscopic examination. For blood samples, these include centrifugation followed by examination of the buffy coat; mini anion-exchange/centrifugation; and the Quantitative Buffy Coat (QBC) technique. For other samples such as spinal fluid, concentration techniques include centrifugation followed by examination of the sediment. Isolation of the parasite by inoculation of rats or mice is a sensitive method, but its use is limited to T. b. rhodesiense. Antibody detection has sensitivity and specificity that are too variable for clinical decisions. In addition, in infections with T. b. rhodesiense, seroconversion occurs after the onset of clinical symptoms and thus is of limited use.
The CDC currently does not offer any serologic or molecular tests for African trypanosomiasis.
Treatment Information
Treatment
Antitrypanosomal treatment is indicated for all persons diagnosed with African trypanosomiasis. Choice of therapy depends on the infecting subspecies of the parasite and on the disease stage. The first line drugs for both first and second stage disease are highly effective. Pentamidine, given by intravenous infusion over 2 hours or by intramuscular injection, is used to treat first stage T. b. gambiense infection. It is generally well tolerated, but adverse reactions of hypoglycemia, injection site pain, diarrhea, nausea and vomiting occur. Suramin is used to treat first stage T. b. rhodesiense. Suramin is also effective against T. b. gambiense, but it is not often used because severe reactions occur in persons who are co-infected with Onchocerca volvulus. Adverse reactions to suramin are frequent, but usually mild and reversible. These include drug rash, nephrotoxicity, and peripheral neuropathy. In rare instances, suramin administration results in a hypersensitivity reaction, and, for this reason, a small test dose is usually given prior to the full first dose.
Second stage T. b. gambiense is treated with eflornithine, which is given in 4 intravenous infusions daily for 14 days. Adverse effects of eflornithine include bone marrow suppression, gastrointestinal symptoms, and seizures. Eflornithine is highly effective, but the difficulty in administering 4 infusions daily in rural African facilities has led to the use of eflornithine (dosed less frequently) in combination with nifurtimox. The efficacy of the combination regimen appears to be at least as high as eflornithine monotherapy. Eflornithine is not effective against T. b. rhodesiense and it is not recommended for treating the East African form of the disease. Melarsoprol, an organoarsenic compound, is the only drug available for treating second stage T. b. rhodesiense. Adverse reactions to melarsoprol can be severe and life-threatening. An encephalopathic reaction occurs in 5-10% of patients with a case-fatality rate of approximately 50% when it occurs. Prednisolone is often given to patients who are being treated with melarsoprol to reduce the risk of encephalopathy. Other adverse reactions observed with melarsoprol include skin reactions, gastrointestinal upset, and peripheral neuropathy. Intravenous injections of melarsoprol are painful and can cause phlebitis. The drug is administered by use of lengthy and complicated dosing schedules, however, an abbreviated 10-day regimen appears promising.
| Species | Drug of choice | Adult Dosage | Pediatric Dosage |
|---|---|---|---|
| T. b. rhodesiense, hemolymphatic stage | Suramin1 | 1 gm IV on days 1,3,5,14, and 212 | 20 mg/kg IV on days 1, 3, 5, 14, and 213 |
| T. b. rhodesiense, CNS involvement | Melarsoprol4 | 2-3.6 mg/kg/day IV x 3 days.5 After 7 days, 3.6 mg/kg/day x 3 days. Give a 3rd series of 3.6 mg/kg/d after 7 days. | 2-3.6 mg/kg/day IV x 3 days.5 After 7 days, 3.6 mg/kg/day x 3 days. Give a 3rd series of 3.6 mg/kg/d after 7 days. |
| T. b. gambiense, Hemolymphatic stage | Pentamidine6 | 4 mg/kg/day IM or IV x 7-10 days | 4 mg/kg/day IM or IV x 7-10 days |
| T. b. gambiense, CNS involvement | Eflornithine7 | 400 mg/kg/day in 4 doses x 14 days | 400 mg/kg/day in 4 doses x 14 days |
Eflornithine
Eflornithine is available for human use in the United States through the Centers for Disease Control and Prevention (CDC).
Note on Treatment in Pregnancy
Note on Treatment During Lactation
Note on Treatment in Pediatric Patients
Pentamidine
Pentamidine is available for human use in the United States.
Note on Treatment in Pregnancy
Note on Treatment During Lactation
Note on Treatment in Pediatric Patients
There is no test of cure for African trypanosomiasis. Patients should be followed with a lumbar puncture every 6 months (or sooner, if symptoms return) for 2 years after treatment to detect a relapse should it occur.
For treatment advice and to obtain suramin, melarsoprol, or eflornithine, physicians should contact the Division of Parasitic Diseases and Malaria (telephone, 404-718-4745; email, parasites@cdc.gov).
More on: Human African trypanosomiasis, WHO![]()
- Pentamidine is also effective against T. b. rhodesiense in the hemolymphatic stage, but suramin may have somewhat higher efficacy.
- A test dose of 100 mg should be given prior to the first dose and the patient should be monitored for hemodynamic stability.
- A test dose of 2 mg/kg should be given prior to the first dose and the patient should be monitored for hemodynamic stability.
- Corticosteroids have been used to prevent melarsoprol encephalopathy.
- The dose of melarsoprol is progressively increased during the first series.
- Suramin is also effective against T. b. gambiense in the hemolymphatic stage.
- Eflornithine (400 mg/kg/d IV in 2 doses x 7 days) given in combination with oral nifurtimox (15 mg/kg/d x 10 days) is also highly effective against T. b. gambiense with CNS involvement (Priotto G et al. Lancet 2009:374; 56-64). Nifurtimox is not FDA-approved for this indication.
DPDx is an education resource designed for health professionals and laboratory scientists. For an overview including prevention and control visit www.cdc.gov/parasites/.
- Page last reviewed: May 3, 2016
- Page last updated: May 3, 2016
- Content source:
- Global Health – Division of Parasitic Diseases and Malaria
- Notice: Linking to a non-federal site does not constitute an endorsement by HHS, CDC or any of its employees of the sponsors or the information and products presented on the site.
- Maintained By:


 ShareCompartir
ShareCompartir